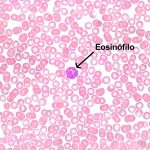
Salud

Archives for Salud - Page 15
Aprende a manejar con estos sencillos pasos
Aprender a manejar puede parecer un poco más complejo o difícil de lo que realmente es. Una vez que estés detrás del volante te darás cuenta de cómo poco a…
¿Por qué Sentimos Miedo a Estar Solos?
El sen humano nace con una naturaleza genética de convivir en comunidad, eso permite que sus derrotas y penas, sean compartidas y mas ligeras, permite que sus logros y triunfos…
Principales riesgos del estrés laboral
Las condiciones del ambiente de trabajo, tienen la facultad de afectar la salud de maneras insospechadas y en este sentido, el llamado estrés laboral se presenta casi que como un…
Consejos para dormir bien durante la noche
Muchas veces ocurre que esperamos con ansias las horas nocturnas para disfrutar finalmente de un sueño placentero y para nuestra sorpresa, por más cansados que estemos, este se hace cada…
Cuál es el trabajo de los eosinófilos en el organismo
Catalogados como una variedad de glóbulos blancos, los eosinófilos hacen parte del sistema inmune del ser humano y por lo tanto se reconocen como células que se encuentran tanto en…